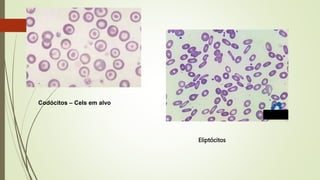
Codócitos – Cels em alvo
Eliptócitos
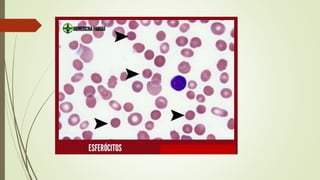
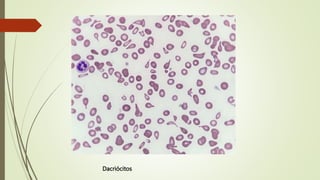
Dacriócitos

Poiquilocitose é um termo que pode aparecer no hemograma e significa aumento no número de hemácias com formato anormal, como esferócitos, dacriócitos e acantócitos. Alterações na membrana das hemácias podem resultar em formatos diferentes, interferindo na sua função. Os principais tipos de poiquilócitos observados no esfregaço sanguíneo incluem esferócitos, dacriócitos, acantócitos, codócitos, eliptócitos, drepanócitos